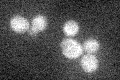
YMR283C
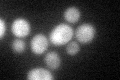
YMR283C

View description
2'-O-ribosyl phosphate transferase, modifies the initiator methionine tRNA at position 64 to distinguish it from elongator methionine tRNA
Localization:
Intensity:
Fold change:
Significance:
-
C’ GFP library in SD
cytosol21.72 -
N' NOP1pr-GFP in SD

N/A0 -
N' TEF2pr-mCherry in SD

N/A0 -
N' NATIVEpr-GFP in SD

N/A0 -
N' TEF2pr-VC and Cyto-VN in SD

N/A0 -
C’ GFP library in SD+DTT
cytosol24.241.11No -
C’ GFP library in SD+H2O2

cytosol21.160.97No -
C’ GFP library in Starvation Media

cytosol18.140.83No -
C’ GFP library on the background of Pup2-DaMP

cytosol -
C’ GFP library on the background of CCT mutant

cytosol26.10711.20171No
